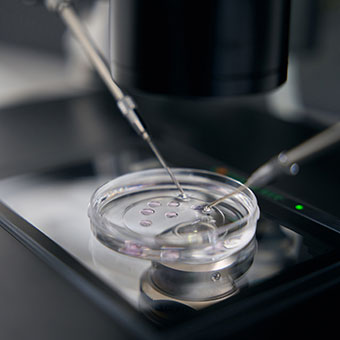
Quality Standards

Servicios
- Home
- Servicios


Análisis de alimentos
Realizamos análisis microbiológicos y fisicoquímicos de todos los alimentos contemplados en el Código Alimentario Español.
- Análisis de composición nutricional.
- Detección de alérgenos en alimentos.
- Certificados analíticos, de composición y de calidad.
- Estudios de envejecimiento y vida comercial de productos alimentarios.
- Análisis de contaminantes.
+25
Años a la vanguardia
del Control de Calidad
del Control de Calidad
Análisis de Aguas
- Aguas de consumo
- Aguas de bebidas envasadas
- Aguas de vertido y residuales
- Aguas de piscinas
- Aguas de balnearios, spa y jacuzzis
- Aguas de baño
- Aguas de EDAR
Análisis de Legionella
- Toma de muestra y análisis de Legionella
- Diseño de sistemas de autocontrol para el mantenimiento higiénico-sanitario en instalaciones de riesgo.
Si desea más información sobre nuestros servicios o la elaboración de un presupuesto adaptado a las necesidades de su empresa, no dude en ponerse en contacto con nosotros. Estaremos encantados de atenderle.
Análisis en Agricultura
- Hongos y parásitos vegetales: Análisis de Verticillium, Phytophthora, Fusarium, etc.
- Detección de nematodos
- Análisis de suelos
- Análisis foliares
- Aguas de riego
- Fertilizantes
- Fitosanitarios

Consultoría y Formación
- Diseño e Implantación de Sistemas de Autocontrol para la Industria Alimentaria: APPCC y Planes Generales de Higiene
- Diseño de sistemas de autocontrol para piscinas de uso público
- Tramitación de inscripción de Registros Sanitarios
- Legislación Alimentaria
- Higiene Alimentaria
- Asesoramiento sobre etiquetado de productos alimentarios
- Innovación e introducción e nuevos productos
- Formación de Manipuladores de alimentos. Curso para el mantenimiento Higiénico Sanitario en instalaciones de riesgo frente a Legionella
- Cursos de formación, a medida, para empresas alimentarias
Auditorías
- De proveedores
- De establecimientos propios
- De cadenas de distribución
- De verificación de Sistemas de Autocontrol (APPCC)
- De seguridad higiénica (BPH)
